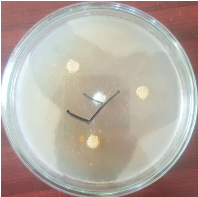

| |
|
|
|
|
| The Chemist Volume 96 | Number 1 |

|
| |
Synthesis, Structural Characterization, and Antimicrobial Evaluation of Dimethyl Methylene Phosphate: An Innovative Phosphorylated Compound with Broad-Spectrum Potential
|
| |
Abstract: Dimethyl Methylene Phosphate was synthesized and its chemical and antimicrobial properties were investigated. Its structure was corroborated by advanced spectroscopic methods (IR, NMR and UV-Visible spectroscopy), underscoring the important role played by the phosphate group. The compound showed potent antibacterial activity with inhibition zones against Gram-negative bacteria such as Alcaligenes faecalis reaching 47 mm. Furthermore, UV-Visible quantitative analysis showed the maximum absorption at 260 nm, affirming its electronic properties. The results establish its potential as a broad-spectrum antimicrobial agent, warranting further exploration into its biological applications and mechanisms of action.
Key Words: Dimethyl Methylene Phosphate (DMP), IR spectroscopy, NMR spectroscopy, antimicrobial activity, phosphate compounds
|
|
|
Introduction
Phosphate-containing compounds play a pivotal role in both biological and chemical systems, serving as integral components in cellular energy transduction, signal trans- duction pathways, and as scaffolds for ad- vanced drug development. The escalating crisis of antimicrobial resistance has underscored the urgency of discovering innovative compounds capable of targeting resistant pathogens effectively. Dimethyl Methylene Phosphate (DMP), a novel phosphorylated compound, represents a significant advance in this domain. Its
distinctive structural features, particularly the phosphoryl (P=O) bond, enable unique interactions with bacterial membranes, potentially disrupting essential cellular functions. In this study, we report the synthesis of DMP, provide a comprehensive evaluation of its antimicrobial activity, and investigate its structural and chemical properties using advanced spectroscopic techniques. These findings aim to shed light on the potential of DMP as a new tool in the fight against antimicrobial resistance.
Experimental
Dimethyl Methylene Phosphate (DMP) was synthesized using pulegone as a precursor. Ina typical procedure, pulegone (0.35 g, 2.25mmol) was dissolved in diethyl ether, and diethylamine was added dropwise while stirring to ensure homogeneity. The resulting mixture was phosphorylated by the gradual addition of phosphoric acid (12 mL) under
controlled conditions at 60°C for 3 hours. Upon completion, the reaction mixture was cooled to ambient temperature, promoting crystallization of the product. Purification was achieved via recrystallization employing a diethyl ether/benzene solvent system, yielding DMP in high purity as confirmed by analytical techniques.
➢ The IR spectrumof DMP exhibited key absorption bands corresponding to its functional groups: 2985 cm⁻¹ (C-H stretching), 1250 cm⁻¹ (P=O stretching), and 1023cm⁻¹ (P-O-C stretching). These findings confirm the successful incorporation of phosphorylated functionalgroups.
➢
o ¹H NMR: Notable signals included a triplet at 0.9 ppm(methyl protons), a singlet at 2.1 ppm (methyl group adjacent to C=O), and multiplets between 4.0-5.0ppm, attributed to methylene groups interacting with polar moieties.
o ¹³C NMR: The spectrum revealed peaks characteristic of distinct carbon environments: 0-50 ppm (aliphatic carbons), 120-150 ppm (aromatic carbons), and 160- 180 ppm (carbonyl carbons).
o ³¹P NMR: A single, sharp peak at 10 ppm confirmed the presence of a single phosphorus environment, indicative of the compound’s organo-phosphate nature.
DMP exhibited maximum absorption at 260 nm, with an extinction coefficient (ε) of 0.127 L·mol⁻¹·cm⁻¹. This absorption is consistent with the electronic transitions associated with the phosphorylated moiety, providing further evidence of the compound’s structural framework.
Biological Part
The antimicrobial efficacy of Dimethyl Methylene Phosphate (DMP) was evaluated using the disk diffusion method across six clinically-relevant bacterial strains: Escherichia coli, Staphylococcus aureus, Pseudomonas aeruginosa, Bacillus subtilis, Klebsiella pneumoniae, and Alcaligenes faecalis. Sterile disks impregnated with DMP at concentrations of 1, 2, 5, and 10 mg/mL were applied to Mueller-Hinton agar plates inoculated with bacterial suspensions. Following 24 hours of incubation at 37°C, inhibition zones were measured, providing quantitative data on the compound's antimicrobial potential.
Results and Discussion
✓ Chemical Characterization
The chemical structure of DMP was confirmed through a comprehensive suite of analytical techniques:
: The spectrum (Figure 1) revealed prominent absorption bands at 1250 cm⁻¹ (P=O stretching) and 1023 cm⁻¹ (P-O-C stretching), consistent with the functional groups characteristic of organophosphates.
The ¹H NMR spectrum displayed key signals, including a triplet at 0.9 ppm (methyl protons), a singlet at 2.1 ppm (methyl adjacent to C=O), and multiplets at 4.0–5.0 ppm (methylene groups). The ¹³C NMR spectrum exhibited peaks at 0–50 ppm (aliphatic carbons), 120–150 ppm (aromatic carbons), and 160–180 ppm (carbonyl carbons). A sharp ³¹P NMR signal at 10 ppm confirmed the presence of a single phosphorus environment.
DMP exhibited a maximum absorption peak at 260 nm, attributed to electronic transitions within the phosphate moiety, which underscores its optical and electronic properties.
 |
✓ Concentration and Solubility: Quantitative analysis determined DMP’s solubility at 0.25 mol/L in ethanol, indicating excellent solubility in polar solvents. This property enhances its applicability in biolog- ical systems, where solubility significantly impacts bioavailability and efficacy.
✓ Antimicrobial Activity: The antimicrobial activity of DMP was assessed across various bacterial strains, with inhibition zones summarized in Table 1. At a concentration of 10 mg/mL, DMP exhibited remarkable efficacy against Gram-negative bacteria, including Alcaligenes faecalis (47 mm) and Escherichia coli (46 mm). Gram-positive bacteria, such as Staphylococcus aureus and Bacillus subtilis, exhibited moderate inhibition zones of 38 mm and 32 mm, respectively. The enhanced activity against Gram-negative strains likely results from DMP's ability to penetrate the outer membrane, destabilizing the bacterial cell envelope and interfering with essential intracellular targets. Figure 2 illustrates the significant inhibition zone observed for A. faecalis, further demonstrating the compound’s broad-spectrum activity. The interaction of the phosphate group with bacterial membranes likely disrupts structural integrity, leading to cellular lysis and death.
|
 |
✓ Mechanism of Action: The proposed mechanism involves membrane di ruption and enzymatic interference. Phosphorylated compounds, such as DMP, integrate into bacterial lipid bilayers, increasing membrane permeability and impairing critical cellular processes. This mechanism provides a plausible explanation for DMP’s significant activity against resistant pathogens, including Pseudomonas aeruginos.
✓ Comparative Analysis: Compared to existing antimicrobial agents, DMP demonstrates several advantages, including high chemical stability, excellent solubility, and consistent efficacy across a range of concentrations. Its robust performance against nosocomial pathogens positions it as a promising candidate for combating antimicrobial resistance. These properties make DMP a valuable addition to the repertoire of anti-microbial agents with potential clinical applications.
Conclusion
Dimethyl Methylene Phosphate (DMP)represents a breakthrough in the development of antimicrobial agents. Its significant activity against both Gram-positive and Gram-negative bacteria, combined with its favoable chemical properties, underscores its potential as a versatile therapeutic candidate. This study establishes a robust foundation for further exploration, including optimization of its structure and elucidation of its molecular interactions in biological systems.
Future research should prioritize in vivo evaluations, comprehensive safety assessments, and detailed mechanistic studies to support its progression toward clinical applications. The incorporation of DMP into pharmaceutical formulations could provide innovative solutions to combat multi-drug-resistant infections, addressing one of the most pressing challenges in modern healthcare.
Acknowledgments
The authors thank Civil Engineering and Environmental Laboratory, Water and Environmental Materials Team, Higher School of Technology in Salé, Mohammed V University in Rabat for providing laboratory resources, including chemical and biology supplies, which supported this research. This study did not receive external funding.
References
- Rodriguez JB, Gallo‐Rodriguez C. The role of the phosphorus atom in drug design. ChemMedChem, 2019, 14(2),190-216. https://doi.org/10.1002/cmdc.20180 0693
- Rafiee Z, Khalafi-Nezhad A, Shahidzadeh M. Multicomponent synthesis of new thiazolylpyrazole derivatives: Green and reusable catalyst, optimized reaction conditions, and DFT study. J. Organomet. Chem., 2018, 869, 165-172. https://doi.org/10.1016/j.toxlet.2018.03.028
- Silva VB, Santos YH, Hellinger R, Mansour S, Delaune A, Legros J, Zinoviev S, Nogueira ES, Orth ES. Organophosphorus chemical security from a peaceful perspective: Sustainable practices in its synthesis, decontamination and detection. Green Chem., 2022, 24(2), 585-613. Gupta A, Sharma S, Goyal S, Sharma
- A, Sharma D. Sustainable and green synthesis of quinoline derivatives: A review. Green Chem., 2022, 24(2), 472-504. https://doi.org/10.1039/D1GC02705K
- Vega MA, Maldonado JR, Rodríguez A, Ortega MG. A new series of hybrid compounds with promising antimalarial activity: Synthesis, biological evaluation, and in silico studies. Bioorg. Med. Chem., 2023, 72, 116961. https://doi.org/10.1016/j.bmc.2023.117512
- Castro-Sánchez E, Drumright LN, Gharbi M, Farrell S, Holmes AH. Mapping antimicrobial stewardship in undergraduate medical, dental, pharmacy, nursing and veterinary education in the United Kingdom.PLoS One, 2016, 11(2), e0150056. https://doi.org/10.1371/journal.pone.0150056
- Koskela H. Use of NMR techniques for toxic organophosphorus compound profiling. J. Chromatogr. B, 2010, 878(17-18), 1365-1381. https://doi.org/10.1016/j.jchromb.20 09.10.030
- Haque R, Buhler DR in Annual Reports on NMR Spectroscopy, Academic Press, 1972, vol 4, Nuclear Magnetic Resonance Spectroscopy in Pesticide Chemistry, pp 237-309. https://doi.org/10.1016/S0066- 4103(08)60346-4
- Pashirova T, Salah-Tazdaït R, Tazdaït D, Masson P. Applications of microbial organophosphate-degrading enzymes to detoxification of organophosphorous compounds for medical countermeasures against poisoning and environmental remediation. Int. J. Mol. Sci., 2024, 25(14),7822. https://doi.org/10.3390/ijms25147822
- Silva-Santana G, Ferreira Silva CM, Botelho Olivella JG, Ferreira Silva I, Oliveira Fernandes LM, Sued-Karam BR, Silva Santos C, Souza C, Mattos-Guaraldi AL. Worldwide survey of Corynebacterium striatum increas- ingly associated with human invasive infections, nosocomial outbreak, and antimicrobial multidrug-resistance, 1976–2020. Arch. Microbiol., 2021, 203,1863-1880. https://doi.org/10.1007/s00203-021-02246-1
|
|
|